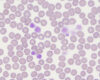
Laboklin: Makrothrombozyten, 1000-fache Vergrößerung, Immersionsöl, Giemsa-Färbung

Der Artikel gibt einen Überblick über Klinik, Pathogenese, Diagnostik und Therapie der equinen Sarkoidose und ordnet die Erkrankung im veterinärmedizinischen Kontext ein.
Hepatopathien: Ursachen, Diagnose und Therapie. Früherkennung, Behandlung und Prävention durch Fütterungs- und Weidemanagement.
Haemonchus contortus: Diagnostik, Behandlung und Prophylaxe bei Schafen, Ziegen und Neuweltkamelen
Zuchthygiene beim Pferd: Pilzinfektionen diagnostizieren, bewerten und therapieren.
Erfahren Sie alles über Biosicherheit bei Neuweltkamelen und wichtige Untersuchungen für Handel und Zucht. Schützen Sie Ihre Herde effektiv.
Erfahren Sie, wie Verhaltensänderungen und Hormonanalysen helfen, den Granulosazelltumor (GZT) bei Stuten frühzeitig zu erkennen. | LABOKLIN aktuell - Pferd
Erfahren Sie, wie Sie bei Pferden Hautuntersuchungen durchführen: Anamnese, Hautgeschabsel, Trichogramm und Pilzkulturen einfach erklärt.
Die Autorin griff das Thema chronischer Gewichtsverlust bei adulten Pferden auf und ging hierbei insbesondere auf die „inflammatory bowl disease“ (IBD) ausführlicher ein.
2023
Für den Nachweis von Infektionserkrankungen steht der Tierärztin und dem Tierarzt ein breites Spektrum an Labortests zur Verfügung.
Das West-Nile-Virus (WNV) wurde in den 1930er Jahren in Afrika entdeckt und beschrieben.
Neben orthopädischen Problemen sind bei Pferden intestinale Erkrankungen die häufigsten Gründe für Vorstellungen in der tierärztlichen Praxis.
Der Vortragende diskutierte einige neue Studien, die auf die Detektion von Silent-Carrier-Pferden eingehen...
2022
Fruchtbarkeitsstörungen der Stute können durch bakterielle Besiedelungen der Geschlechtsorgane verursacht werden.
Die klinischen Bilder gastrointestinaler Beschwerden beim Pferd sind vielfältig.
Lebererkrankungen kommen bei Equiden relativ häufig vor. Die Ursachen hierfür können neben Giftpflanzen, Toxinen, Parasitosen und Neoplasien auch bakterielle sowie virale Infektionserreger sein.
Die sogenannte „Druse“ wird durch das grampositive, β-hämolysierende Bakterium Streptococcus equi subspezies equi hervorgerufen.
Die Aufarbeitung von Atemwegserkrankungen des Pferdes beruht einerseits auf der Anamnese, der klinischen Untersuchung, dem endoskopischen Befund und Lungenfunktionstests, andererseits sind aber auch Laboruntersuchungen wie die Zytologie von Probenmaterial aus den Atemwegen (TBS – Tracheobronchialsekret und BAL – Bronchoalveolarlavage) wichtige Bausteine im diagnostischen Prozess.
2021
Thrombozyten, auch Blutplättchen genannt, sind ein wichtiger Bestandteil der Blutgerinnung...
Dass für Pferde eine gute Futterzusammensetzung und -qualität wichtig ist, ist inzwischen allgemein bekannt und so erfreuen sich Futtermittelanalysen großer Beliebtheit. Vergessen wird aber oft das Tränkwasser.
Kürzlich wurde die Nomenklatur der equinen Atemwegserkrankungen überarbeitet...
Beim Sommerekzem handelt es sich um die häufigste juckende Hauterkrankung beim Pferd.
Erfahren Sie, wie das equine Coronavirus (ECoV) Pferde betrifft, welche Symptome auftreten und wie sich das Virus verbreitet.
2020
Der Verdauungsapparat von Pferden ist auf die optimale Verwertung pflanzlicher Nahrung ausgelegt.
Nichtinvasive Diagnostik- und Therapieansätze erlangen auch in der Veterinärmedizin seit einigen Jahren eine immer größere Bedeutung.
Vor oder zu Beginn der Zuchtsaison wird besonderes Augenmerk auf die Stuten gerichtet, die im vergangenen Jahr nicht aufgenommen oder verfohlt haben.
Während der Zuchtsaison gilt es, die Zuchttauglichkeit bei allen Stuten zu beurteilen, die für eine Belegung vorgesehen sind. Hierzu gehört neben der gynäkologischen Untersuchung eine mikrobiologische Untersuchung von Zervix- oder Uterustupfern.
2019
Unter Alopezie versteht man eine generalisierte oder lokal auftretende Haarlosigkeit.
PSSM ist eine Störung im Kohlenhydratstoffwechsel, die durch die Anhäufung anormaler Polysaccharide wie auch die übermäßige Anhäufung normaler Zuckermoleküle im Muskel gekennzeichnet ist.
Die aktuelle Resistenzproblematik, insbesondere bei den kleinen Strongyliden, macht die Therapie von Endoparasitosen beim Pferd zu einer Herausforderung.
Ein 12 Jahre alter Angloaraber-Wallach wurde aufgrund multipler Hautläsionen vorgestellt. Die Läsionen bestanden seit etwa zwei Wochen und die betroffenen Stellen umfassten die Nase, das linke Vorderbein, sowie beide Hinterbeine und Hufballen.